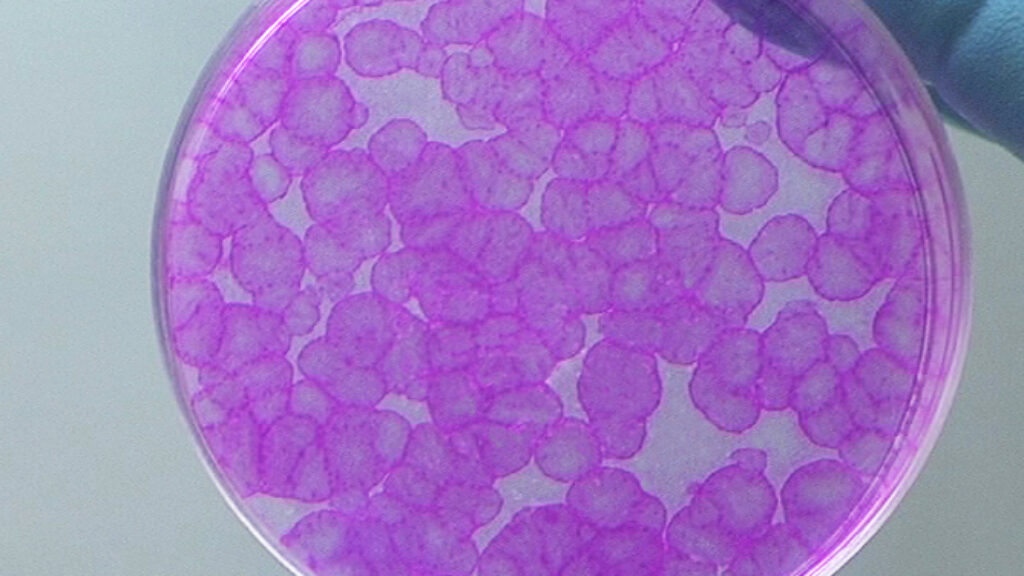

In the summer of 2015, a 7-year-old named Hassan was admitted to the burn unit of the Ruhr University Children’s Hospital in Bochum, Germany, with red, oozing wounds from head to toe.
It wasn’t a fire that took his skin. It was a bacterial infection, resulting from an incurable genetic disorder. Called junctional epidermolysis bullosa, the condition deprives the skin of a protein needed to hold its layers together and leads to large, painful lesions. For kids, it’s often fatal. And indeed, Hassan’s doctors told his parents, Syrian refugees who had fled to Germany, the young boy was dying.
The doctors tried one last thing to save him. They cut out a tiny, unblistered patch of skin from the child’s groin and sent it to the laboratory of Michele de Luca, an Italian stem cell expert who heads the Center for Regenerative Medicine at the University of Modena and Reggio Emilia. De Luca’s team used a viral vector to ferry into Hassan’s skin cells a functional version of the gene LAMB3, which codes for laminin, the protein that anchors the surface of the skin to the layers below.
advertisement Then the scientists grew the modified cells into sheets big enough for Ruhr University plastic surgeons Tobias Hirsch and Maximilian Kueckelhaus to graft onto Hassan’s raw, bedridden body, which they did over the course of that October, November, and the following January.
It worked better than the boy’s doctors could have imagined. In 2017, de Luca, Hirsch, Kueckelhaus, and their colleagues reported that Hassan was doing well, living like a normal boy in his lab-grown skin. At the time though, there was still a big question on all their minds: How long would it last? Would the transgenic stem cells keep replenishing the skin or would they sputter out? Or worse — could they trigger a cascade of cancer-causing reactions?
advertisement Today, the same team is out with an update. Five years and five months after the initial intervention, Hassan is still, for the most part, thriving in fully functional skin that has grown with the now-teenager. He is attending school, and playing sports with his friends and siblings, though he avoids swimming due to blistering in the areas that weren’t replaced by the lab-grown skin. One of his favorite activities is a pedal-powered go kart. There are no signs his modified stem cells have lost their steam, and no traces of tumors to be found. The encouraging follow-up data has been instrumental in moving forward a larger clinical trial of the approach, offering hope to the 500,000 epidermolysis bullosa patients worldwide currently living without treatment options.
‘We were astonished by the speedy recovery,’ Kueckelhaus, now at University Hospital Muenster, told STAT via email. But experience from skin transplantation in other settings made him and his colleagues wary of the grafts failing as the months and years wore on. Thankfully, wrote Kueckelhaus, those fears never materialized. ‘We are very happy to be able to prove that none of these complications appeared and the genetically modified skin remains 100% stable. The chances are good that he will be able to live a relatively normal life.’
Over the last five years, Hassan’s team of doctors and researchers has put his new skin through a battery of tests — checking it for sensitivity to hot and cold, water retention, pigmentation and hemoglobin levels, and if it had developed all the structures you’d expect healthy skin to have, including sweat glands and hair follicles. Across the board, the engineered skin appeared normal, without the need for moisturizers or medical ointments. The only flaw they found was that Hassan’s skin wasn’t as sensitive to fine touch, especially in his lower right leg. This mild neuropathy they attributed not to the graft itself, but to how that limb was prepared — doctors used a more aggressive technique that might have damaged the nerves there. The team also used molecular techniques to trace the cells they’d grown in the lab as they divided and expanded over Hassan’s body. They found that all the different kinds of cells composing the boy’s new skin were being generated by a small pool of self-renewing stem cells called holoclone-forming cells, carrying the Italian team’s genetic correction.
‘This was quite an insight into the biology of the epidermis,’ said de Luca. It’s an insight he expects will have huge consequences for any efforts to advance similar gene therapies for treating other diseases affecting the skin. ‘You have to have the holoclone-forming cells in your culture if you want to have long-lasting epidermis,’ he said.
The approach pioneered by de Luca’s team will soon be headed for its biggest clinical test yet, after nearly a decade of fits and starts. They expect to begin recruiting for a multi-center Phase 2/3 trial sometime next year.
De Luca first successfully treated a junctional EB patient in 2005. But then a change to European Union laws governing cell and gene therapies forced his team to stop work while they found ways to comply with the new rules. It took years of paperwork, building a manufacturing facility, and spinning out a small biotech company called Holostem to be ready to begin clinical research again. Hassan came along right as they were gearing up for a Phase 1 trial, but data from the boy’s case, which was granted approval under a compassionate use provision, convinced regulators that the cell grafts could move to larger, more pivotal trials, according to de Luca.
‘We didn’t cure the disease,’ he told STAT. ‘But the skin has been restored, basically permanently. We did not observe a single blister in five years. The wound healing is normal, the skin is robust. From this point of view, the quality of life is not even comparable to what it was before.’
https://www.statnews.com/2021/12/08/last-gasp-gene-therapy-saved-syrian-refugee-clinical-trial-starting/